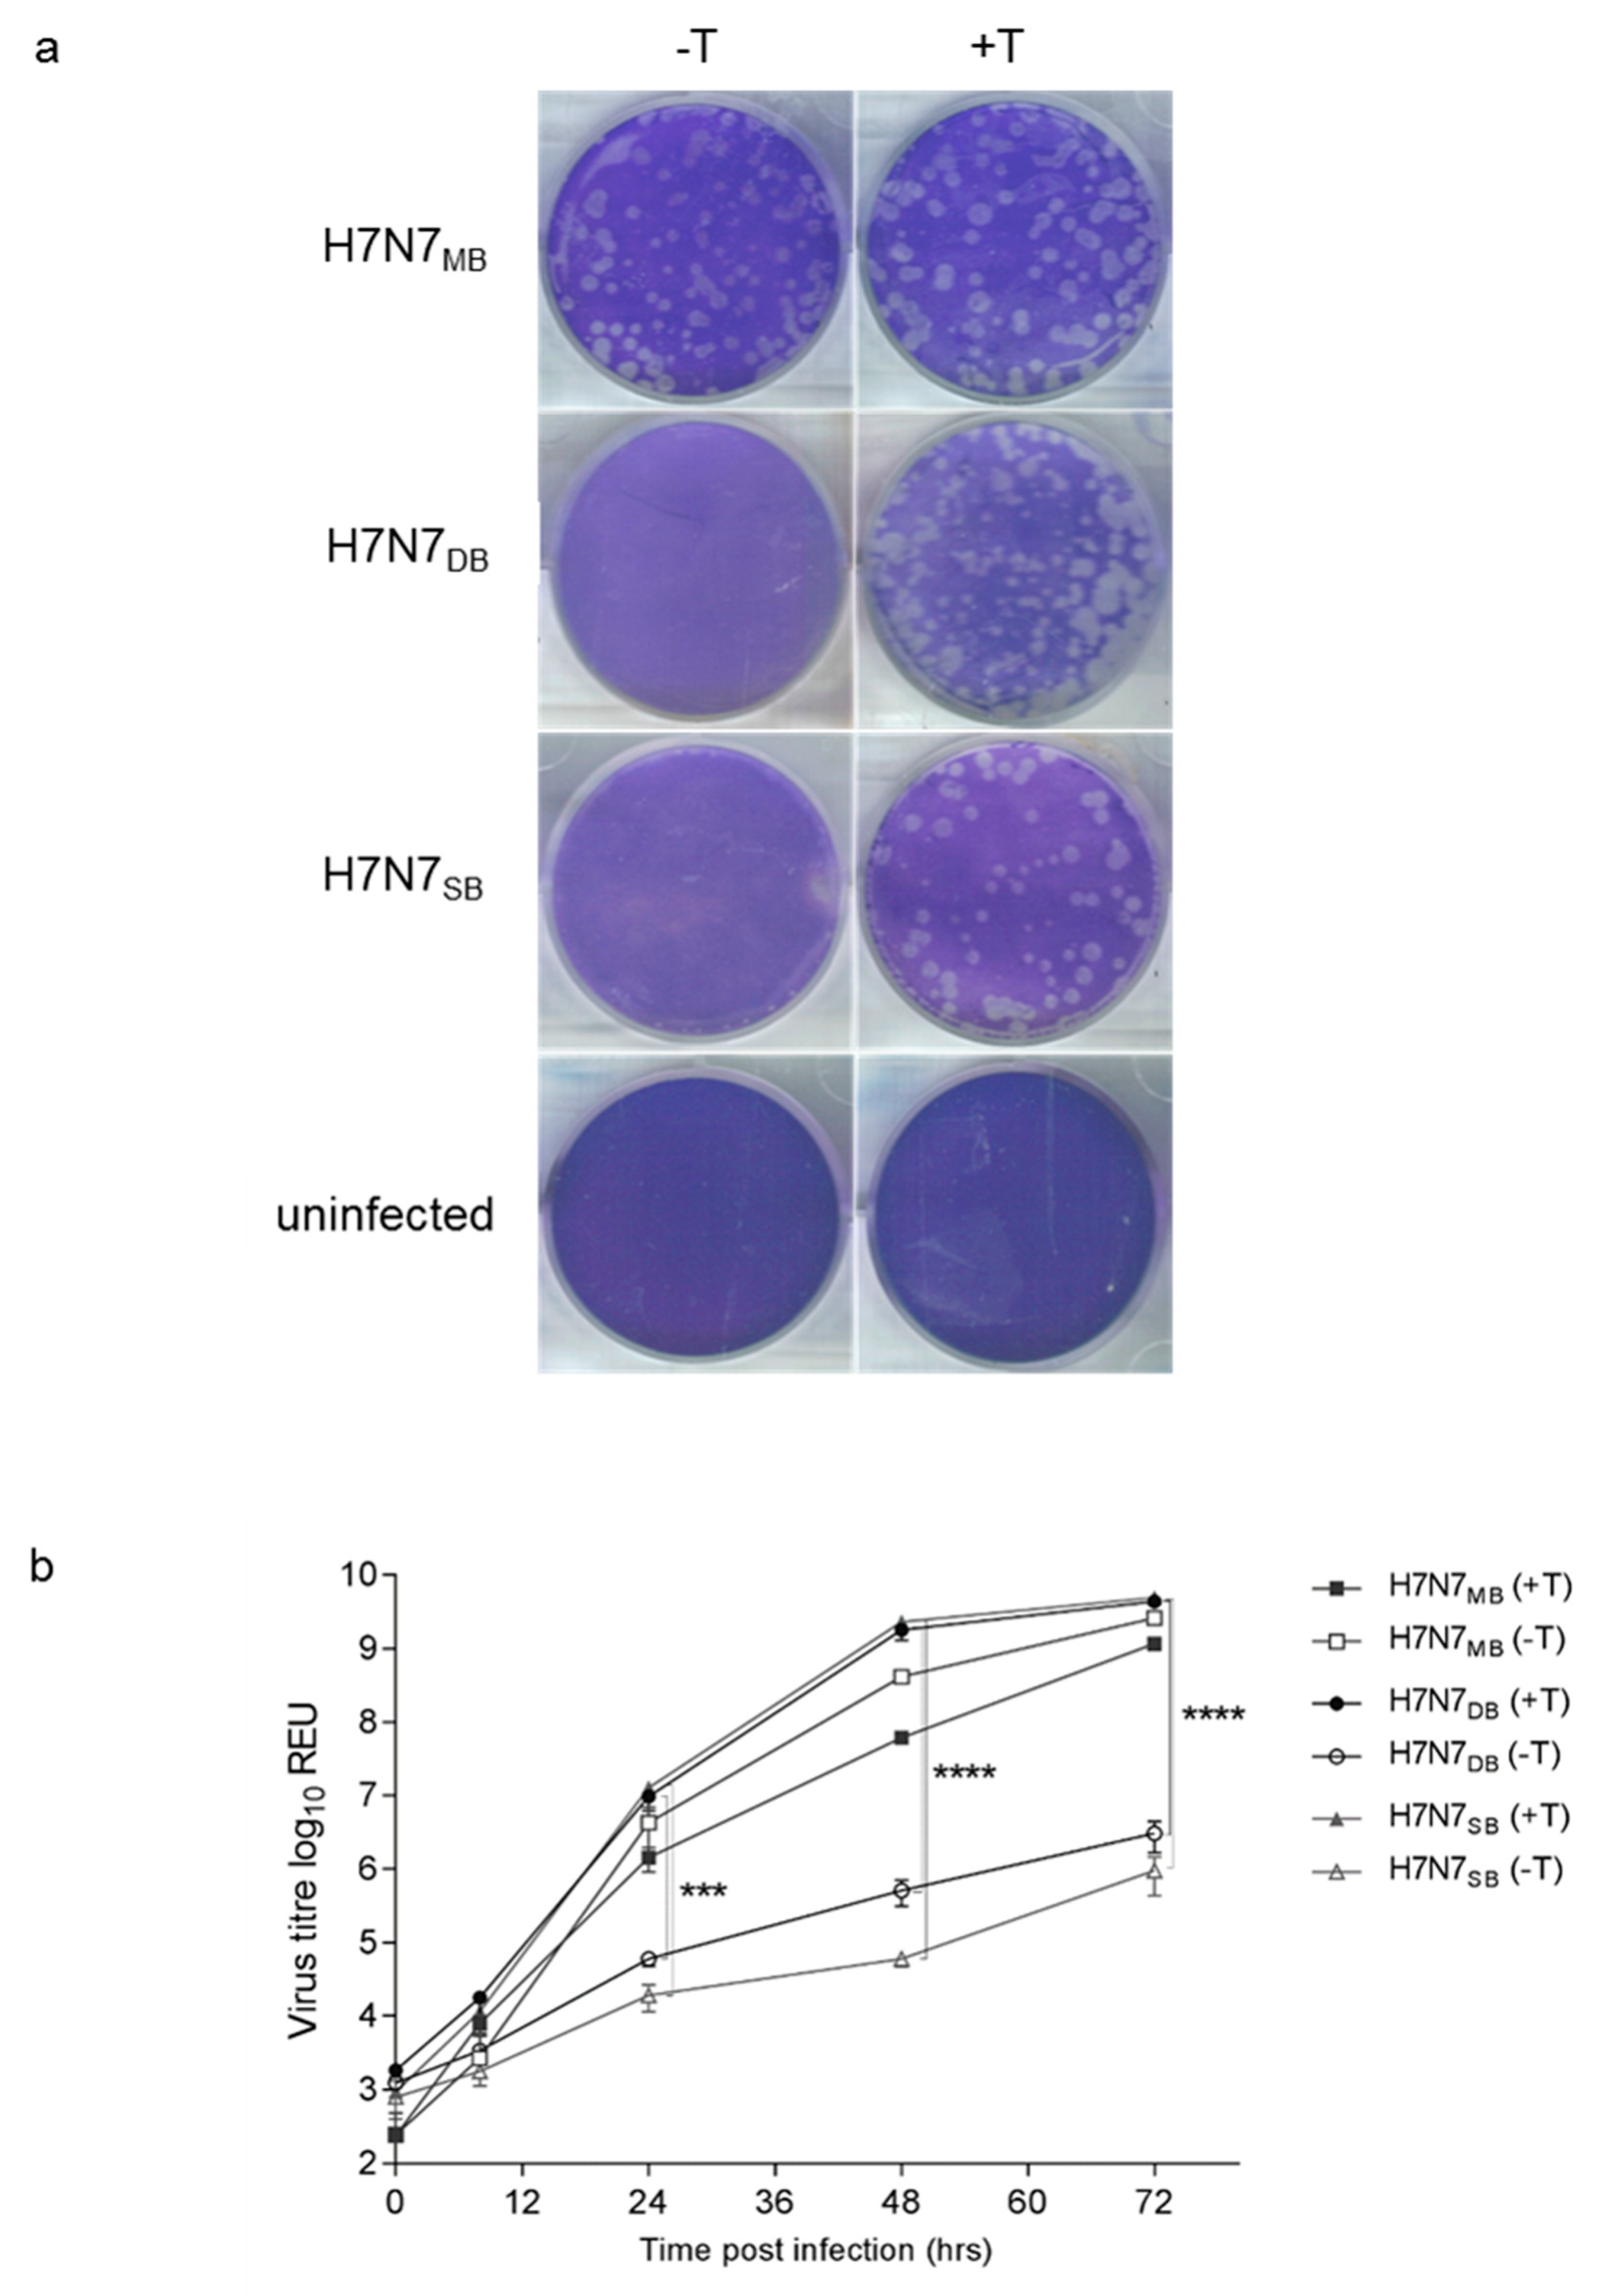
Viruses 12 00920 g001 Viruses 12 00920 g001

The Emergence of H7N7 Highly Pathogenic Avian Influenza Virus from Low Pathogenicity Avian Influenza Virus Using an in ovo Embryo Culture Model
Abstract
1. Introduction
2. Materials and Methods
2.1. Ethics and Biosafety Statement
2.2. Cells
2.3. Viruses
2.4. Titration According to Plaque-Forming Units (pfu)
2.5. Multi-Cycle Growth Kinetics
2.6. Viral RNA Isolation
2.7. M-Gene Reverse Transcription RealTime (RRT)-PCR
2.8. Intravenous Pathogenicity Index (IVPI) Determination
2.9. Embryonated Fowls’ Eggs (EFEs)
2.9.1. Virus Isolation and Propagation in EFEs
2.9.2. Allantoic Fluid Passage Experiments of H7N7DB
2.9.3. Tissue Tropism in EFEs
2.10. Sanger Sequencing
2.11. Deep Sequencing
2.12. Statistics
3. Results
3.1. Rescue of Recombinant RG Viruses
3.2. A MBCS Reflects a Trypsin-Independent Phenotype In Vitro
3.3. A MBCS in the HA Protein Is Required for a HP Phenotype In Vivo
3.4. H7N7DB Passage in Allantoic Fluid
3.5. Comparative Pathotyping of H7N7 Wt and Recombinant RG Viruses in Chicken Embryo Tissues
3.6. Emergence of HPAIV after H7N7DB Passage in Chicken Embryo Tissues
3.7. Confirming the Phenotype of the HP Progeny Viruses by IVPI
3.8. Generation of HPAIV from H7N7SB Was Unsuccessful after Multiple Passages in Chicken Embryos
4. Discussion
Supplementary Materials
Author Contributions
Funding
Acknowledgments
Conflicts of Interest
References
- King, A.M.Q.; Adams, M.J.; Carstens, E.B.; Lefkowitz, E.J. (Eds.) International Committee on Taxonomy of Viruses: Family—Orthomyxoviridae. In Virus Taxonomy, 9th ed.; Elsevier: London, UK, 2012; pp. 749–761. [Google Scholar]
- OIE. OIE Terrestrial Manual 2018. Chapter 3.3.4—Avian Influenza (Infection with Avian Influenza Viruses). Available online: http://www.oie.int/fileadmin/Home/eng/Health_standards/tahm/3.03.04_AI.pdf (accessed on 5 June 2018).
- Alexander, D.J. An overview of the epidemiology of avian influenza. Vaccine 2007, 25, 5637–5644. [Google Scholar] [CrossRef] [PubMed]
- OFFLU. Influenza A Cleavage Sites. Available online: http://www.offlu.net/fileadmin/home/en/resource-centre/pdf/Influenza_A_Cleavage_Sites.pdf (accessed on 17 January 2020).
- Luczo, J.M.; Stambas, J.; Durr, P.A.; Michalski, W.P.; Bingham, J. Molecular pathogenesis of H5 highly pathogenic avian influenza: The role of the haemagglutinin cleavage site motif. Rev. Med. Virol. 2015, 25, 406–430. [Google Scholar] [CrossRef] [PubMed]
- Soda, K.; Cheng, M.C.; Yoshida, H.; Endo, M.; Lee, S.H.; Okamatsu, M.; Sakoda, Y.; Wang, C.H.; Kida, H. A low pathogenic H5N2 influenza virus isolated in Taiwan acquired high pathogenicity by consecutive passages in chickens. J. Vet. Med. Sci. 2011, 73, 767–772. [Google Scholar] [CrossRef] [PubMed][Green Version]
- Tian, G.; Zhang, S.; Li, Y.; Bu, Z.; Liu, P.; Zhou, J.; Li, C.; Shi, J.; Yu, K.; Chen, H. Protective efficacy in chickens, geese and ducks of an H5N1-inactivated vaccine developed by reverse genetics. Virology 2005, 341, 153–162. [Google Scholar] [CrossRef] [PubMed]
- Horimoto, T.; Kawaoka, Y. Reverse genetics provides direct evidence for a correlation of hemagglutinin cleavability and virulence of an avian influenza A virus. J. Virol. 1994, 68, 3120–3128. [Google Scholar] [CrossRef]
- Ohuchi, R.; Ohuchi, M.; Garten, W.; Klenk, H.D. Human influenza virus hemagglutinin with high sensitivity to proteolytic activation. J. Virol. 1991, 65, 3530–3537. [Google Scholar] [CrossRef]
- Klenk, H.D.; Rott, R.; Orlich, M.; Blodorn, J. Activation of influenza A viruses by trypsin treatment. Virology 1975, 68, 426–439. [Google Scholar] [CrossRef]
- Lee, C.W.; Lee, Y.J.; Senne, D.A.; Suarez, D.L. Pathogenic potential of North American H7N2 avian influenza virus: A mutagenesis study using reverse genetics. Virology 2006, 353, 388–395. [Google Scholar] [CrossRef][Green Version]
- Gohrbandt, S.; Veits, J.; Hundt, J.; Bogs, J.; Breithaupt, A.; Teifke, J.P.; Weber, S.; Mettenleiter, T.C.; Stech, J. Amino acids adjacent to the haemagglutinin cleavage site are relevant for virulence of avian influenza viruses of subtype H5. J. Gen. Virol. 2011, 92, 51–59. [Google Scholar] [CrossRef]
- Bogs, J.; Veits, J.; Gohrbandt, S.; Hundt, J.; Stech, O.; Breithaupt, A.; Teifke, J.P.; Mettenleiter, T.C.; Stech, J. Highly pathogenic H5N1 influenza viruses carry virulence determinants beyond the polybasic hemagglutinin cleavage site. PLoS ONE 2010, 5, e11826. [Google Scholar] [CrossRef]
- Ping, J.; Selman, M.; Tyler, S.; Forbes, N.; Keleta, L.; Brown, E.G. Low-pathogenic avian influenza virus A/turkey/Ontario/6213/1966 (H5N1) is the progenitor of highly pathogenic A/turkey/Ontario/7732/1966 (H5N9). J. Gen. Virol. 2012, 93, 1649–1657. [Google Scholar] [CrossRef] [PubMed]
- Westbury, H.A.; Turner, A.J.; Kovesdy, L. The Pathogenicity of Three Australian Fowl Plague Viruses For Chickens, Turkeys And Ducks. Vet. Microbiol. 1979, 4, 223–234. [Google Scholar] [CrossRef]
- Deshpande, K.L.; Fried, V.A.; Ando, M.; Webster, R.G. Glycosylation affects cleavage of an H5N2 influenza virus hemagglutinin and regulates virulence. Proc. Natl. Acad. Sci. USA 1987, 84, 36–40. [Google Scholar] [CrossRef] [PubMed]
- Perdue, M.L.; Garcia, M.; Senne, D.; Fraire, M. Virulence-associated sequence duplication at the hemagglutinin cleavage site of avian influenza viruses. Virus Res. 1997, 49, 173–186. [Google Scholar] [CrossRef]
- Garcia, M.; Crawford, J.M.; Latimer, J.W.; RiveraCruz, E.; Perdue, M.L. Heterogeneity in the haemagglutinin gene and emergence of the highly pathogenic phenotype among recent H5N2 avian influenza viruses from Mexico. J. Gen. Virol. 1996, 77, 1493–1504. [Google Scholar] [CrossRef]
- Horimoto, T.; Rivera, E.; Pearson, J.; Senne, D.; Krauss, S.; Kawaoka, Y.; Webster, R.G. Origin and molecular changes associated with emergence of a highly pathogenic H5N2 influenza virus in Mexico. Virology 1995, 213, 223–230. [Google Scholar] [CrossRef]
- Naeem, K. The Avian Influenza H7N3 Outbreak in South Central Asia. In Proceedings of the fourth International Symposium on Avian Influenza 1997, Avian Diseases; Swayne, D.E., Slemons, R.D., Eds.; American Association of Avian Pathologists: Athens, GA, USA, 2003; pp. 31–35. [Google Scholar]
- Banks, J.; Speidel, E.S.; Moore, E.; Plowright, L.; Piccirillo, A.; Capua, I.; Cordioli, P.; Fioretti, A.; Alexander, D.J. Changes in the haemagglutinin and the neuraminidase genes prior to the emergence of highly pathogenic H7N1 avian influenza viruses in Italy. Arch. Virol. 2001, 146, 963–973. [Google Scholar] [CrossRef]
- Suarez, D.L.; Senne, D.A.; Banks, J.; Brown, I.H.; Essen, S.C.; Lee, C.W.; Manvell, R.J.; Mathieu-Benson, C.; Moreno, V.; Pedersen, J.C.; et al. Recombination resulting in virulence shift in avian influenza outbreak, Chile. Emerg. Infect. Dis. 2004, 10, 693–699. [Google Scholar] [CrossRef]
- De Wit, J.J.; Koch, G.; Fabri, T.H.; Elbers, A.R. A cross-sectional serological survey of the Dutch commercial poultry population for the presence of low pathogenic avian influenza virus infections. Avian Pathol. 2004, 33, 565–570. [Google Scholar] [CrossRef][Green Version]
- Pasick, J.; Handel, K.; Robinson, J.; Copps, J.; Ridd, D.; Hills, K.; Kehler, H.; Cottam-Birt, C.; Neufeld, J.; Berhane, Y.; et al. Intersegmental recombination between the haemagglutinin and matrix genes was responsible for the emergence of a highly pathogenic H7N3 avian influenza virus in British Columbia. J. Gen. Virol. 2005, 86, 727–731. [Google Scholar] [CrossRef]
- Berhane, Y.; Hisanaga, T.; Kehler, H.; Neufeld, J.; Manning, L.; Argue, C.; Handel, K.; Hooper-McGrevy, K.; Jonas, M.; Robinson, J.; et al. Highly pathogenic avian influenza virus A (H7N3) in domestic poultry, Saskatchewan, Canada, 2007. Emerg. Infect. Dis. 2009, 15, 1492–1495. [Google Scholar] [CrossRef] [PubMed]
- Seekings, A.H.; Slomka, M.J.; Russell, C.; Howard, W.A.; Choudhury, B.; Nunez, A.; Londt, B.Z.; Cox, W.; Ceeraz, V.; Thoren, P.; et al. Direct evidence of H7N7 avian influenza virus mutation from low to high virulence on a single poultry premises during an outbreak in free range chickens in the UK, 2008. Infect. Genet. Evol. 2018, 64, 13–31. [Google Scholar] [CrossRef] [PubMed]
- Defra. Highly Pathogenic Avian Influenza H7N7 (AIV2015/02; formerly AIV SOS2015/0001). In Table-egg Laying Hens, Preston, July 2015. Situation at 11:00 on Friday 28 August 2015. Available online: https://www.gov.uk/government/uploads/system/uploads/attachment_data/file/469948/ai-epi-report-july-2015.pdf (accessed on 8 January 2017).
- Iglesias, I.; Martinez, M.; Munoz, M.J.; de la Torre, A.; Sanchez-Vizcaino, J.M. First case of highly pathogenic avian influenza in poultry in Spain. Transbound. Emerg. Dis. 2010, 57, 282–285. [Google Scholar] [CrossRef] [PubMed]
- Bonfanti, L.; Monne, I.; Tamba, M.; Santucci, U.; Massi, P.; Patregnani, T.; Loli Piccolomini, L.; Natalini, S.; Ferri, G.; Cattoli, G.; et al. Highly pathogenic H7N7 avian influenza in Italy. Vet. Rec. 2014, 174, 382. [Google Scholar] [CrossRef]
- Dietze, K.; Graaf, A.; Homeier-Bachmann, T.; Grund, C.; Forth, L.; Pohlmann, A.; Jeske, C.; Wintermann, M.; Beer, M.; Conraths, F.J.; et al. From low to high pathogenicity-Characterization of H7N7 avian influenza viruses in two epidemiologically linked outbreaks. Transbound. Emerg. Dis. 2018. [Google Scholar] [CrossRef]
- Killian, M.L.; Kim-Torchetti, M.; Hines, N.; Yingst, S.; DeLiberto, T.; Lee, D.H. Outbreak of H7N8 Low Pathogenic Avian Influenza in Commercial Turkeys with Spontaneous Mutation to Highly Pathogenic Avian Influenza. Genome Announc. 2016, 4, e00457-16. [Google Scholar] [CrossRef]
- Mulatti, P.; Zecchin, B.; Monne, I.; Vieira, J.T.; Dorotea, T.; Terregino, C.; Lorenzetto, M.; Piccolomini, L.L.; Santi, A.; Massi, P.; et al. H7N7 Highly Pathogenic Avian Influenza in Poultry Farms in Italy in 2016. Avian Dis. 2017, 61, 261–266. [Google Scholar] [CrossRef]
- Lee, D.H.; Torchetti, M.K.; Killian, M.L.; Berhane, Y.; Swayne, D.E. Highly Pathogenic Avian Influenza A(H7N9) Virus, Tennessee, USA, March 2017. Emerg. Infect. Dis. 2017, 23, 1860–1863. [Google Scholar] [CrossRef]
- Lam, T.T.; Zhou, B.; Wang, J.; Chai, Y.; Shen, Y.; Chen, X.; Ma, C.; Hong, W.; Chen, Y.; Zhang, Y.; et al. Dissemination, divergence and establishment of H7N9 influenza viruses in China. Nature 2015, 522, 102–105. [Google Scholar] [CrossRef]
- Yang, J.R.; Liu, M.T. Human infection caused by an avian influenza A (H7N9) virus with a polybasic cleavage site in Taiwan, 2017. J. Formos. Med. Assoc. 2017, 116, 210–212. [Google Scholar] [CrossRef]
- Zhu, W.; Zhou, J.; Li, Z.; Yang, L.; Li, X.; Huang, W.; Zou, S.; Chen, W.; Wei, H.; Tang, J.; et al. Biological characterisation of the emerged highly pathogenic avian influenza (HPAI) A(H7N9) viruses in humans, in mainland China, 2016 to 2017. Eurosurveillance 2017, 22. [Google Scholar] [CrossRef] [PubMed]
- Perdue, M.; Crawford, J.; Garcia, M.; Latimer, J.E.; Swayne, D. Occurrence and Possible Mechanisms of Cleavage-Site Insertions in the Avian Influenza Hemagglutinin Gene. In Proceedings of the fourth International Symposium on Avian Influenza 1997, Avian Diseases; Swayne, D.E., Slemons, R.D., Eds.; American Association of Avian Pathologists: Atlanta, GA, USA, 2003; pp. 182–193. [Google Scholar]
- Nao, N.; Yamagishi, J.; Miyamoto, H.; Igarashi, M.; Manzoor, R.; Ohnuma, A.; Tsuda, Y.; Furuyama, W.; Shigeno, A.; Kajihara, M.; et al. Genetic Predisposition to Acquire a Polybasic Cleavage Site for Highly Pathogenic Avian Influenza Virus Hemagglutinin. mBio 2017, 8, e02298-16. [Google Scholar] [CrossRef] [PubMed]
- Lee, C.W.; Lee, Y.J.; Swayne, D.; Senne, D.; Linares, D.J.; Suarez, D. Assessing potential pathogenicity of avian influenza virus: Current and experimental system. Avian Dis. 2007, 51, 260–263. [Google Scholar] [CrossRef] [PubMed]
- Fusaro, A.; Tassoni, L.; Milani, A.; Hughes, J.; Salviato, A.; Murcia, P.R.; Massi, P.; Zamperin, G.; Bonfanti, L.; Marangon, S.; et al. Unexpected Interfarm Transmission Dynamics during a Highly Pathogenic Avian Influenza Epidemic. J. Virol. 2016, 90, 6401–6411. [Google Scholar] [CrossRef] [PubMed]
- Lee, D.H.; Torchetti, M.K.; Killian, M.L.; Swayne, D.E. Deep sequencing of H7N8 avian influenza viruses from surveillance zone supports H7N8 high pathogenicity avian influenza was limited to a single outbreak farm in Indiana during 2016. Virology 2017, 507, 216–219. [Google Scholar] [CrossRef]
- Luczo, J.M.; Tachedjian, M.; Harper, J.A.; Payne, J.S.; Butler, J.M.; Sapats, S.I.; Lowther, S.L.; Michalski, W.P.; Stambas, J.; Bingham, J. Evolution of high pathogenicity of H5 avian influenza virus: Haemagglutinin cleavage site selection of reverse-genetics mutants during passage in chickens. Sci. Rep. 2018, 8, 11518. [Google Scholar] [CrossRef]
- Brugh, M. Highly pathogenic virus recovered from chickens infected with mildly pathogenic 1986 isolates of H5N2 avian influenza virus. Avian Dis. 1988, 32, 695–703. [Google Scholar] [CrossRef]
- Li, S.Q.; Orlich, M.; Rott, R. Generation of seal influenza virus variants pathogenic for chickens, because of hemagglutinin cleavage site changes. J. Virol. 1990, 64, 3297–3303. [Google Scholar] [CrossRef]
- Horimoto, T.; Kawaoka, Y. Molecular changes in virulent mutants arising from avirulent avian influenza viruses during replication in 14-day-old embryonated eggs. Virology 1995, 206, 755–759. [Google Scholar] [CrossRef]
- Ohuchi, M.; Orlich, M.; Ohuchi, R.; Simpson, B.E.; Garten, W.; Klenk, H.D.; Rott, R. Mutations at the cleavage site of the hemagglutinin after the pathogenicity of influenza virus A/chick/Penn/83 (H5N2). Virology 1989, 168, 274–280. [Google Scholar] [CrossRef]
- Perdue, M.L.; Wainright, P.; Palmieri, S.; Brugh, M. In ovo competition between distinct virus populations in an avian influenza isolate. Avian Dis. 1989, 33, 695–706. [Google Scholar] [CrossRef] [PubMed]
- Ito, T.; Goto, H.; Yamamoto, E.; Tanaka, H.; Takeuchi, M.; Kuwayama, M.; Kawaoka, Y.; Otsuki, K. Generation of a highly pathogenic avian influenza A virus from an avirulent field isolate by passaging in chickens. J. Virol. 2001, 75, 4439–4443. [Google Scholar] [CrossRef] [PubMed]
- Scholtissek, C.; Muller, K.; Herzog, S.; Frese, K. Multiplication of influenza A viruses with cleavable and non-cleavable haemagglutinin in chicken embryo membranes or organs, and cell cultures derived therefrom. J. Gen. Virol. 1988, 69, 2155–2164. [Google Scholar] [CrossRef] [PubMed]
- Rott, R.; Reinacher, M.; Orlich, M.; Klenk, H.D. Cleavability of hemagglutinin determines spread of avian influenza viruses in the chorioallantoic membrane of chicken embryo. Arch. Virol. 1980, 65, 123–133. [Google Scholar] [CrossRef]
- Park, C.H.; Ozaki, H.; Takada, A.; Kida, H.; Ochiai, K.; Umemura, T. Primary target cells of virulent strains of type A influenza virus in chicken embryos. Avian Pathol. 2001, 30, 269–272. [Google Scholar] [CrossRef]
- Feldmann, A.; Schafer, M.K.; Garten, W.; Klenk, H.D. Targeted infection of endothelial cells by avian influenza virus A/FPV/Rostock/34 (H7N1) in chicken embryos. J. Virol. 2000, 74, 8018–8027. [Google Scholar] [CrossRef]
- Mutinelli, F.; Hablovarid, H.; Capua, I. Avian embryo susceptibility to Italian H7N1 avian influenza viruses belonging to different lineages. Avian Dis. 2003, 47, 1145–1149. [Google Scholar] [CrossRef]
- Metreveli, G.; Zohari, S.; Ejdersund, A.; Berg, M. Phylogenetic analysis of the hemagglutinin gene of low pathogenic avian influenza virus H7N7 strains in mallards in Northern Europe. Avian Dis. 2010, 54, 453–456. [Google Scholar] [CrossRef]
- Bashiruddin, J.B.; Gould, A.R.; Westbury, H.A. Molecular pathotyping of two avian influenza viruses isolated during the Victoria 1976 outbreak. Aust. Vet. J. 1992, 69, 140–142. [Google Scholar] [CrossRef]
- Slomka, M.J.; Seekings, A.H.; Mahmood, S.; Thomas, S.; Puranik, A.; Watson, S.; Byrne, A.M.P.; Hicks, D.; Nunez, A.; Brown, I.H.; et al. Unexpected infection outcomes of China-origin H7N9 low pathogenicity avian influenza virus in turkeys. Sci. Rep. 2018, 8, 7322. [Google Scholar] [CrossRef]
- Howard, W.; Hayman, A.; Lackenby, A.; Whiteley, A.; Londt, B.; Banks, J.; McCauley, J.; Barclay, W. Development of a reverse genetics system enabling the rescue of recombinant avian influenza virus A/Turkey/England/50-92/91 (H5N1). Avian Dis. 2007, 51, 393–395. [Google Scholar] [CrossRef] [PubMed]
- Elleman, C.J.; Barclay, W.S. The M1 matrix protein controls the filamentous phenotype of influenza A virus. Virology 2004, 321, 144–153. [Google Scholar] [CrossRef] [PubMed]
- Slomka, M.J.; Pavlidis, T.; Coward, V.J.; Voermans, J.; Koch, G.; Hanna, A.; Banks, J.; Brown, I.H. Validated RealTime reverse transcriptase PCR methods for the diagnosis and pathotyping of Eurasian H7 avian influenza viruses. Influenza Other Respir. Viruses 2009, 3, 151–164. [Google Scholar] [CrossRef] [PubMed]
- Spackman, E.; Senne, D.A.; Myers, T.J.; Bulaga, L.L.; Garber, L.P.; Perdue, M.L.; Lohman, K.; Daum, L.T.; Suarez, D.L. Development of a real-time reverse transcriptase PCR assay for type A influenza virus and the avian H5 and H7 hemagglutinin subtypes. J. Clin. Microbiol. 2002, 40, 3256–3260. [Google Scholar] [CrossRef] [PubMed]
- Löndt, B.Z.; Nunez, A.; Banks, J.; Nili, H.; Johnson, L.K.; Alexander, D.J. Pathogenesis of highly pathogenic avian influenza A/turkey/Turkey/1/2005 H5N1 in Pekin ducks (Anas platyrhynchos) infected experimentally. Avian Pathol. 2008, 37, 619–627. [Google Scholar] [CrossRef] [PubMed]
- Reed, L.J.; Muench, H. A simple method of estimating fifty per cent endpoints. Am. J. Epidemiol. 1938, 27, 493–497. [Google Scholar] [CrossRef]
- Bolger, A.M.; Lohse, M.; Usadel, B. Trimmomatic: A flexible trimmer for Illumina sequence data. Bioinformatics 2014, 30, 2114–2120. [Google Scholar] [CrossRef]
- Li, H.; Durbin, R. Fast and accurate long-read alignment with Burrows-Wheeler transform. Bioinformatics 2010, 26, 589–595. [Google Scholar] [CrossRef]
- Li, H.; Handsaker, B.; Wysoker, A.; Fennell, T.; Ruan, J.; Homer, N.; Marth, G.; Abecasis, G.; Durbin, R.; 1000 Genome Project Data Processing Subgroup. The Sequence Alignment/Map format and SAMtools. Bioinformatics 2009, 25, 2078–2079. [Google Scholar] [CrossRef]
- Schrauwen, E.J.; Bestebroer, T.M.; Munster, V.J.; de Wit, E.; Herfst, S.; Rimmelzwaan, G.F.; Osterhaus, A.D.; Fouchier, R.A. Insertion of a multibasic cleavage site in the haemagglutinin of human influenza H3N2 virus does not increase pathogenicity in ferrets. J. Gen. Virol. 2011, 92, 1410–1415. [Google Scholar] [CrossRef]
- Munster, V.J.; Schrauwen, E.J.; De Wit, E.; Van den Brand, J.M.; Bestebroer, T.M.; Herfst, S.; Rimmelzwaan, G.F.; Osterhaus, A.D.; Fouchier, R.A. Insertion of a multibasic cleavage motif into the hemagglutinin of a low-pathogenic avian influenza H6N1 virus induces a highly pathogenic phenotype. J. Virol. 2010, 84, 7953–7960. [Google Scholar] [CrossRef] [PubMed]
- Kandeil, A.; Bagato, O.; Zaraket, H.; Debeauchamp, J.; Krauss, S.; El-Shesheny, R.; Webby, R.J.; Ali, M.A.; Kayali, G. Proteolytic enzymes in embryonated chicken eggs sustain the replication of egg-grown low-pathogenicity avian influenza viruses in cells in the absence of exogenous proteases. J. Virol. Methods 2014, 202, 28–33. [Google Scholar] [CrossRef] [PubMed][Green Version]
- Horimoto, T.; Kawaoka, Y. Biologic effects of introducing additional basic amino acid residues into the hemagglutinin cleavage site of a virulent avian influenza virus. Virus. Res. 1997, 50, 35–40. [Google Scholar] [CrossRef]
- Vey, M.; Orlich, M.; Adler, S.; Klenk, H.D.; Rott, R.; Garten, W. Hemagglutinin activation of pathogenic avian influenza viruses of serotype H7 requires the protease recognition motif R-X-K/R-R. Virology 1992, 188, 408–413. [Google Scholar] [CrossRef]
- Brugh, M.; Beck, J.R. Recovery of minority subpopulations of highly pathogenic avian influenza virus. In Proceedings of the third International Symposium on Avian Influenza; Easterday, B.C., Beard, C.W., Eds.; American Association of Avian Pathologists: Atlanta, GA, USA, 1992; pp. 166–174. [Google Scholar]
- Animals (Scientific Procedures) Act 1986. Available online: https://www.legislation.gov.uk/ukpga/1986/14/2018-10-01 (accessed on 17 July 2020).
- Perdue, M.L.; Wainright, P.O.; Brugh, M. Effects of chicken embryo age on time to death following infection by avian influenza viruses: Implications for distinguishing highly pathogenic isolates. Virus Res. 1990, 16, 137–152. [Google Scholar] [CrossRef]
- Monne, I.; Fusaro, A.; Nelson, M.I.; Bonfanti, L.; Mulatti, P.; Hughes, J.; Murcia, P.R.; Schivo, A.; Valastro, V.; Moreno, A.; et al. Emergence of a highly pathogenic avian influenza virus from a low-pathogenic progenitor. J Virol. 2014, 88, 4375–4388. [Google Scholar] [CrossRef]
- Graaf, A.; Ulrich, R.; Maksimov, P.; Scheibner, D.; Koethe, S.; Abdelwhab, E.M.; Mettenleiter, T.C.; Beer, M.; Harder, T. A viral race for primacy: Co-infection of a natural pair of low and highly pathogenic H7N7 avian influenza viruses in chickens and embryonated chicken eggs. Emerg. Microbes. Infect. 2018, 7, 204. [Google Scholar] [CrossRef]
- Veits, J.; Weber, S.; Stech, O.; Breithaupt, A.; Graber, M.; Gohrbandt, S.; Bogs, J.; Hundt, J.; Teifke, J.P.; Mettenleiter, T.C.; et al. Avian influenza virus hemagglutinins H2, H4, H8, and H14 support a highly pathogenic phenotype. Proc. Natl. Acad. Sci. USA 2012, 109, 2579–2584. [Google Scholar] [CrossRef]
- Gohrbandt, S.; Veits, J.; Breithaupt, A.; Hundt, J.; Teifke, J.P.; Stech, O.; Mettenleiter, T.C.; Stech, J. H9 avian influenza reassortant with engineered polybasic cleavage site displays a highly pathogenic phenotype in chicken. J. Gen. Virol. 2011, 92, 1843–1853. [Google Scholar] [CrossRef]
- Stieneke-Gröber, A.; Vey, M.; Angliker, H.; Shaw, E.; Thomas, G.; Roberts, C.; Klenk, H.D.; Garten, W. Influenza virus hemagglutinin with multibasic cleavage site is activated by furin, a subtilisin-like endoprotease. EMBO J. 1992, 11, 2407–2414. [Google Scholar] [CrossRef]
- Reid, S.M.; Brookes, S.M.; Nunez, A.; Banks, J.; Parker, C.D.; Ceeraz, V.; Russell, C.; Seekings, A.; Thomas, S.S.; Puranik, A.; et al. Detection of non-notifiable H4N6 avian influenza virus in poultry in Great Britain. Vet. Microbiol. 2018, 224, 107–115. [Google Scholar] [CrossRef] [PubMed]
- Bellairs, R.; Osmond, M. Chapter 8—Gut, Coelom and Respiratory System. In Atlas of Chick Development, 3rd ed.; Bellairs, R., Osmond, M., Eds.; Academic Press: Boston, MA, USA, 2014; pp. 77–89. [Google Scholar]
- Shahsavandi, S.; Ebrahimi, M.M.; Mohammadi, A.; Zarrin Lebas, N. Impact of chicken-origin cells on adaptation of a low pathogenic influenza virus. Cytotechnology 2013, 65, 419–424. [Google Scholar] [CrossRef] [PubMed]
- Petersen, H.; Matrosovich, M.; Pleschka, S.; Rautenschlein, S. Replication and adaptive mutations of low pathogenic avian influenza viruses in tracheal organ cultures of different avian species. PLoS ONE 2012, 7, e42260. [Google Scholar] [CrossRef]
- Iqbal, M.; Essen, S.C.; Xiao, H.; Brookes, S.M.; Brown, I.H.; McCauley, J.W. Selection of variant viruses during replication and transmission of H7N1 viruses in chickens and turkeys. Virology 2012, 433, 282–295. [Google Scholar] [CrossRef] [PubMed][Green Version]
- Matrosovich, M.; Zhou, N.; Kawaoka, Y.; Webster, R. The surface glycoproteins of H5 influenza viruses isolated from humans, chickens, and wild aquatic birds have distinguishable properties. J. Virol. 1999, 73, 1146–1155. [Google Scholar] [CrossRef]
- Byrd-Leotis, L.; Cummings, R.D.; Steinhauer, D.A. The Interplay between the Host Receptor and Influenza Virus Hemagglutinin and Neuraminidase. Int. J. Mol. Sci. 2017, 18, 1541. [Google Scholar] [CrossRef] [PubMed]
- Banks, J.; Plowright, L. Additional glycosylation at the receptor binding site of the hemagglutinin (HA) for H5 and H7 viruses may be an adaptation to poultry hosts, but does it influence pathogenicity? Avian Dis. 2003, 47, 942–950. [Google Scholar] [CrossRef]
- Post, J.; Peeters, B.; Cornelissen, J.B.; Vervelde, L.; Rebel, J.M. Contribution of the NS1 gene of H7 avian influenza virus strains to pathogenicity in chickens. Viral Immunol. 2013, 26, 396–403. [Google Scholar] [CrossRef]
- Vignuzzi, M.; Stone, J.K.; Arnold, J.J.; Cameron, C.E.; Andino, R. Quasispecies diversity determines pathogenesis through cooperative interactions in a viral population. Nature 2006, 439, 344–348. [Google Scholar] [CrossRef]
- Zaraket, H.; Baranovich, T.; Kaplan, B.S.; Carter, R.; Song, M.S.; Paulson, J.C.; Rehg, J.E.; Bahl, J.; Crumpton, J.C.; Seiler, J.; et al. Mammalian adaptation of influenza A(H7N9) virus is limited by a narrow genetic bottleneck. Nat. Commun. 2015, 6, 6553. [Google Scholar] [CrossRef]
- Moya, A.; Elena, S.F.; Bracho, A.; Miralles, R.; Barrio, E. The evolution of RNA viruses: A population genetics view. Proc. Natl. Acad. Sci. USA 2000, 97, 6967–6973. [Google Scholar] [CrossRef] [PubMed]
- Capua, I.; Alexander, D.J. Control of influenza in animals. In Textbook of Influenza; Webster, R.G., Monto, A.S., Braciale, T.J., Lamb, R.A., Eds.; John Wiley & Sons: Chichester, UK, 2013; pp. 337–351. [Google Scholar]
- Vandegrift, K.J.; Sokolow, S.H.; Daszak, P.; Kilpatrick, A.M. Ecology of avian influenza viruses in a changing world. Ann. N. Y. Acad. Sci. 2010, 1195, 113–128. [Google Scholar] [CrossRef] [PubMed]
- EU. COUNCIL DIRECTIVE 2005/94/EC of 20 December 2005 on Community Measures for the Control of Avian Influenza and Repealing Directive 92/40/EEC. Available online: http://eur-lex.europa.eu/legal-content/EN/TXT/PDF/?uri=CELEX:32005L0094&from=en (accessed on 14 April 2016).

| Virus Name | Cleavage Site Nucleotide and Amino Acid Sequence | CS Sequence Origin |
|---|---|---|
| Wildtype (wt) virus | ||
| England-08 | CCCGAAATCCCAAAG AGA AAG AAA AGA / GGCCTATTT P E I P K R K K R / G L F | Wt H7N7 HPAIV A/chicken/England/11406/2008 |
| Sweden-08 | CCTGAAATCCCAAAG AAA - - - - - - AGA / GGCCTATTT P E I P K K - - R / G L F | Wt H7N7 LPAIV A/mallard/Sweden/100993/2008 |
| Recombinant-RG virus | ||
| H7N7MB H7N7MB + | CCCGAAATCCCAAAG AGA AAG AAA AGA / GGCCTATTT P E I P K R K K R / G L F | CS derived from HPAIV England-08 |
| H7N7DB H7N7DB + | CCCGAAATCCCAAAG AAA - - - - - - AGA / GGCCTATTT P E I P K K - - R / G L F | Putative LP precursor virus to the HPAIV outbreak |
| H7N7SB H7N7SB + | CCCGAAATCCCAAAG GGA - - - - - - AGA / GGCCTATTT P E I P K G - - R / G L F | Typical European and Asian LP CS motif |
| P2: E14, E1 | P2: E14, E11 | P3: E14, E11, E9 | |
|---|---|---|---|
| PB2 | 0 | 6 | 4 |
| PB1 | 0 | 0 | 0 |
| PA | 0 | 8 (A20T, D27N, E59K) | 24 (A20T, D27N, E59K, A85T, I100V) |
| HA * | 0 | 1 (G227E) | 1 (G227E) |
| NP | 0 | 0 | 0 |
| NA | 0 | 1 (T51K) | 1 (T51K) |
| M | 0 | 0 | 3 (V15I) |
| NS | 0 | 0 | 0 |
© 2020 by the authors. Licensee MDPI, Basel, Switzerland. This article is an open access article distributed under the terms and conditions of the Creative Commons Attribution (CC BY) license (http://creativecommons.org/licenses/by/4.0/).
Share and Cite
Seekings, A.H.; Howard, W.A.; Nuñéz, A.; Slomka, M.J.; Banyard, A.C.; Hicks, D.; Ellis, R.J.; Nuñéz-García, J.; Hartgroves, L.C.; Barclay, W.S.; et al. The Emergence of H7N7 Highly Pathogenic Avian Influenza Virus from Low Pathogenicity Avian Influenza Virus Using an in ovo Embryo Culture Model. Viruses 2020, 12, 920. https://doi.org/10.3390/v12090920
Seekings AH, Howard WA, Nuñéz A, Slomka MJ, Banyard AC, Hicks D, Ellis RJ, Nuñéz-García J, Hartgroves LC, Barclay WS, et al. The Emergence of H7N7 Highly Pathogenic Avian Influenza Virus from Low Pathogenicity Avian Influenza Virus Using an in ovo Embryo Culture Model. Viruses. 2020; 12(9):920. https://doi.org/10.3390/v12090920
Chicago/Turabian StyleSeekings, Amanda H., Wendy A. Howard, Alejandro Nuñéz, Marek J. Slomka, Ashley C. Banyard, Daniel Hicks, Richard J. Ellis, Javier Nuñéz-García, Lorian C. Hartgroves, Wendy S. Barclay, and et al. 2020. "The Emergence of H7N7 Highly Pathogenic Avian Influenza Virus from Low Pathogenicity Avian Influenza Virus Using an in ovo Embryo Culture Model" Viruses 12, no. 9: 920. https://doi.org/10.3390/v12090920
APA StyleSeekings, A. H., Howard, W. A., Nuñéz, A., Slomka, M. J., Banyard, A. C., Hicks, D., Ellis, R. J., Nuñéz-García, J., Hartgroves, L. C., Barclay, W. S., Banks, J., & Brown, I. H. (2020). The Emergence of H7N7 Highly Pathogenic Avian Influenza Virus from Low Pathogenicity Avian Influenza Virus Using an in ovo Embryo Culture Model. Viruses, 12(9), 920. https://doi.org/10.3390/v12090920

